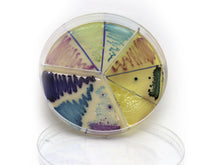
Carregar imagem no visualizador da galeria, Placa Accumast

Peso: 260,0g
Saiba mais acessando nosso site: https://elevenup.gpages.com.br/innovate-leite
* Pacote com 4 placas com capacidade de analisar até 12 amostras
** Acompanha kit de trabalho com tubos e swabs para a aplicação do amostra nas placas.
Prazo de entrega:
PAC - 25 dias
SEDEX - 15 dias